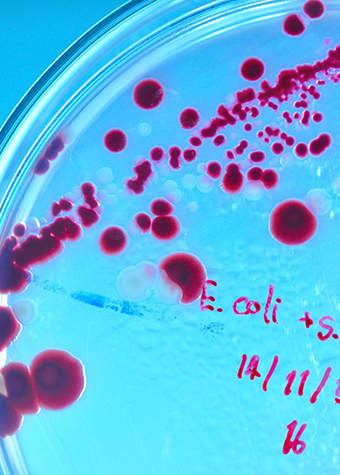

Majoring in Biological Sciences
Coursework, facilities and research opportunities will prepare you for the most competitive graduate schools, professional schools and science-related jobs. Almost every course has a hands-on lab. Our location in coastal New England gives you access to estuaries and salt marshes and the ability to interact with industry scientists at nearby research facilities. Some students work on research projects during a semester program at the Marine Biological Laboratory in Woods Hole, Massachusetts. Our proximity to Pfizer Central Research and major medical centers at Yale and in Boston allow research collaborations for faculty and students.
Research opportunities
You will be encouraged to work with one of your professors on an independent research project. Many students present their research at conferences and publish papers with faculty in peer-reviewed journals. Areas of faculty-student research include cell and molecular biology, genetics and evolution, developmental biology, ecology and physiology. Major supporters of this research include the National Science Foundation and the National Institutes of Health.
Biology students often participate in the Connecticut College Summer Research Program, where they receive a stipend and free campus housing while working on independent research projects with a professor. Recent student projects have included:
- investigating bacterial populations in a nearby salt marsh using molecular tools
- mapping genes that affect flight in fruit flies
- studying cancer-associated proteins involved in cell division
Facilities
We offer hands-on experiences with electron and fluorescent microscopes, digital image analysis, cell culture and real-time polymerase chain reaction in our well-equipped labs located within our newly renovated Science Center. Our equipment and spaces are complemented by an equally impressive living laboratory—the College's 750-acre Arboretum—and the resources of our interdisciplinary Goodwin-Niering Center for the Environment.